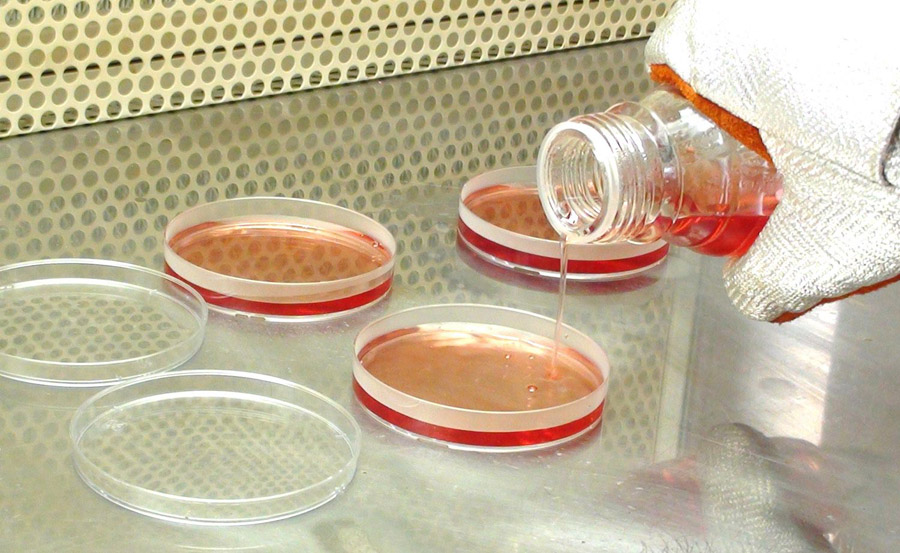

Ofrecemos una gama de medios de cultivo microbiológicos diseñados para pruebas de control de calidad en las industrias farmacéutica, alimentaria, de bebidas y tratamiento de aguas. A continuación, se detallan los medios cultivos principales:
- Medio Caso
- Medio Endo
- Medio Sabouraud
- Medio Centrimide
- Agua Peptona
- Otros.